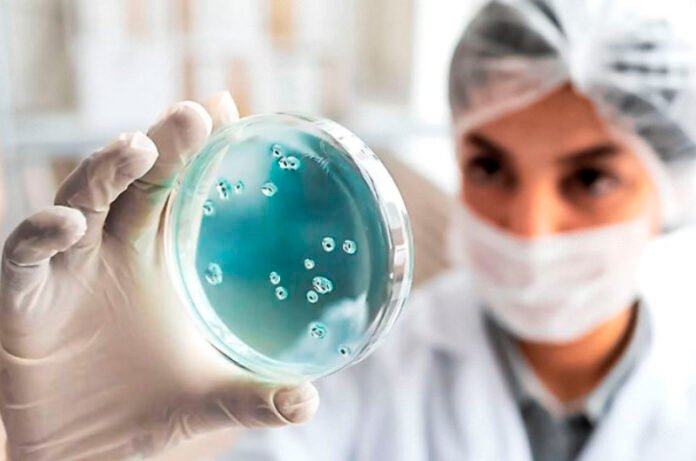
vir

El sistema de salud del Estado de México confirmó los dos primeros casos de viruela del mono o viruela símica en pacientes mexiquenses, se trata de dos hombres de 30 y 41 años de edad, respectivamente, uno de ellos con antecedentes de un viaje internacional.
El subdirector de Epidemiología del Instituto de Salud del Estado de México (ISEM), Víctor Durán Mendieta, informó que el primer caso se trata de un paciente hombre, de 30 años, que tiene como antecedente un viaje a Austria, quien se desempeña como trabajador sexual, teniendo contacto con dos personas durante su viaje.
El segundo caso es de un paciente hombre, de 41 años, que fue captado por los sistemas de salud de la Ciudad de México, quien además tiene un diagnóstico de VIH, como antecedente residió en Quintana Roo, en donde se presume pudo darse el contagio.
Sin embargo, al ser residente del Estado de México, se notifica al sistema estatal de salud para su seguimiento. Estos dos casos se identificaron en los municipios de Chimalhuacán y Zumpango, en la entidad.
¿Cómo toman la muestra?
La muestra respectiva, añadió, se recibe en el Laboratorio Estatal de Salud Pública y posteriormente se deriva al Instituto de Diagnóstico y Referencia Epidemiológicos (InDRE), para correr la prueba respectiva y días después se recibe el resultado. Esta muestra se toma directamente de las lesiones presentadas en la piel.
El proceso también implica que los pacientes se mantengan bajo aislamiento, mientras se obtiene el resultado y una vez que se cuenta con éste, se inicia el tratamiento respectivo, el cual dependerá de cada paciente, pues aún no existe un tratamiento específico para esta enfermedad.
¿Cuál es la letalidad?
El especialista detalló que la viruela símica es una enfermedad de muy baja letalidad, que si bien no tiene un tratamiento específico, el indicador de mortalidad es muy bajo, ya que a nivel mundial es de prácticamente cero.
“Desde el momento en que se empezaron a emitir las alertas a nivel mundial, a través de la Organización Mundial de la Salud, de la Organización Panamericana de la Salud y de la Secretaría de Salud Federal, nosotros hemos estado muy atentos, de tal manera que cada caso sospechoso que se ha notificado, le hemos dado puntual seguimiento”.
Identifica los síntomas La sintomatología, añadió, generalmente se centra en la inflamación de los ganglios en diversas zonas del cuerpo, y posteriormente pueden aparecer nódulos y estos se pueden reventar para después formarse una costra.
También se presenta fiebre, malestar general, situación de cansancio, dolores musculares y articulares. Las lesiones en la piel se presentan en distintas partes del cuerpo, como en los brazos, piernas e incluso en la zona de los genitales, de tal manera que es prácticamente lo que detona la sospecha para el diagnóstico.
Con información de Milenio